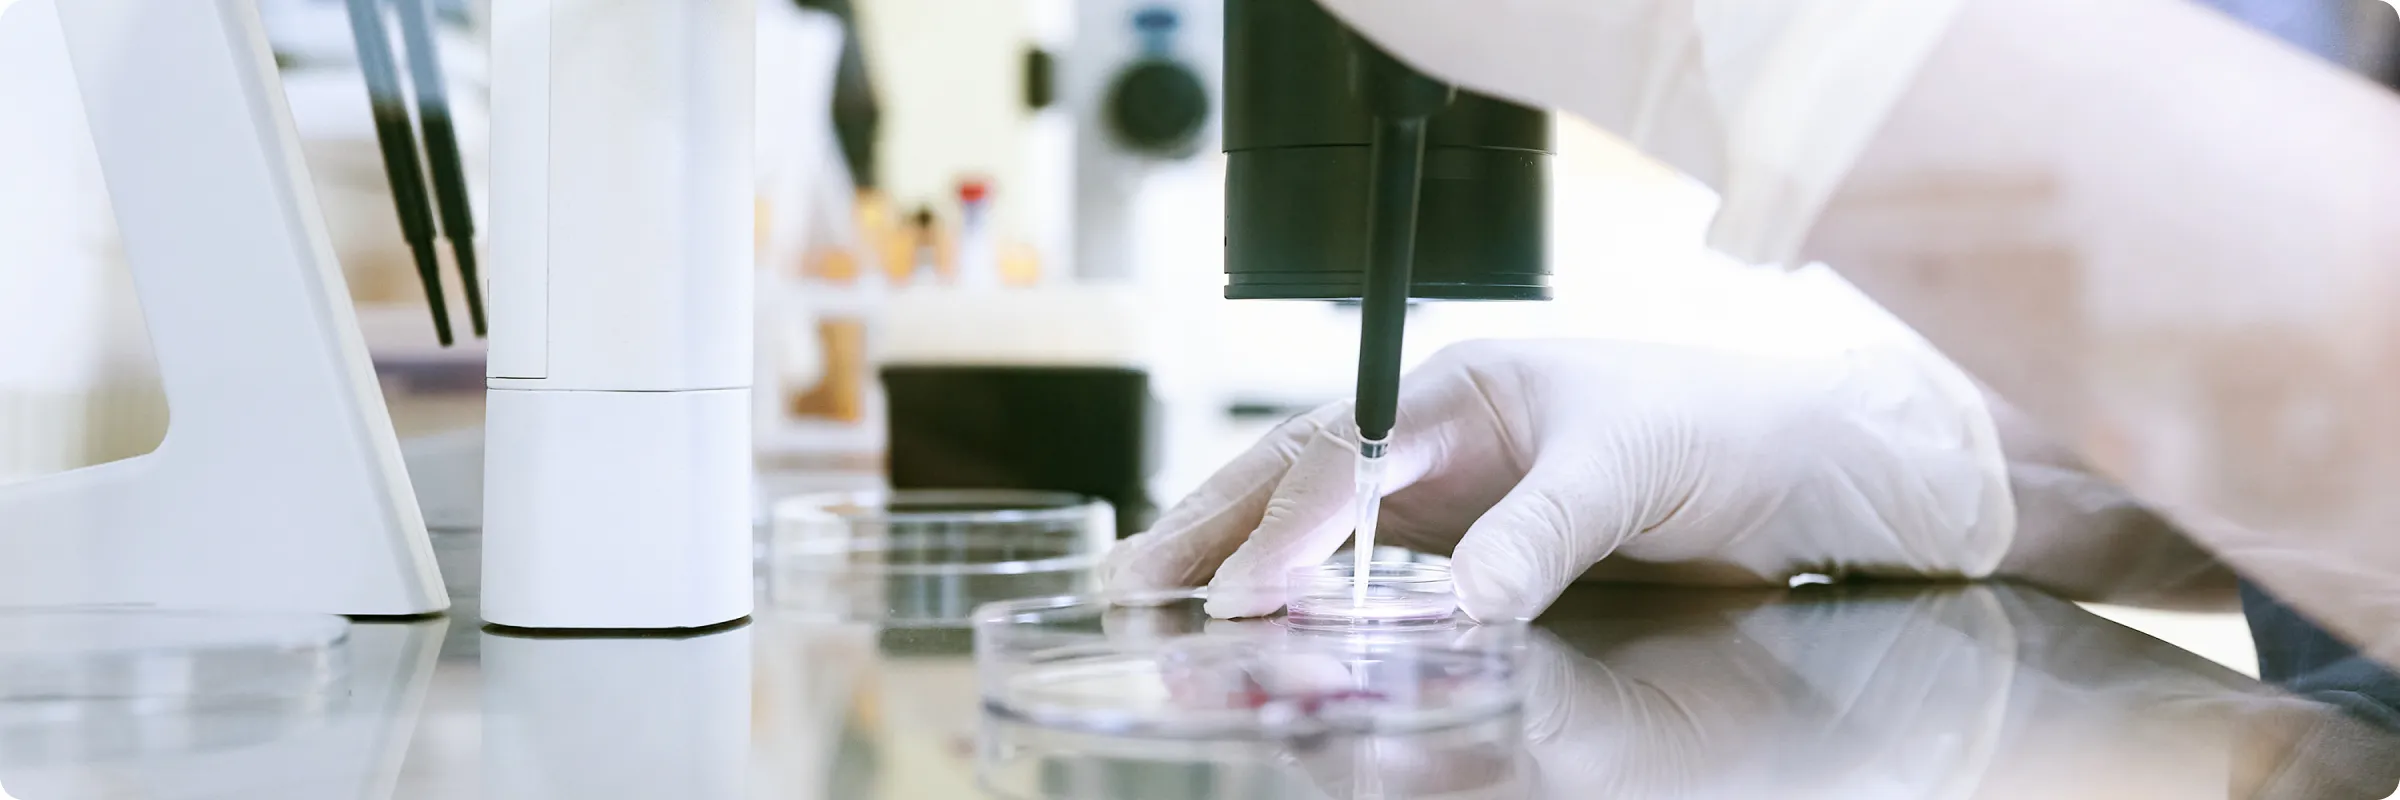

网站里面的搜索
治疗预订形式
到被来院的
诊疗科、中心
找诊疗科
通知

朝医护人员、学生的方向
2026年度"实习领导者培训讲习会"开课的通知

朝医护人员、学生的方向
关于新人护理人员训练"医疗机关纳入进修"

新闻
NEW公关杂志"tobutaimu vol.46春天号"发刊

新闻
比NEW繁殖门诊关于"黄金周的停诊"

媒体信息
在面向医学学生、存在于的网站"HOKUTO"上关于NEW[媒体信息]这家医院的临床研究程序刊登了

新闻
NEW公关杂志"tobutaimu vol.46春天号"发刊
新闻
比NEW繁殖门诊关于"黄金周的停诊"

新闻
请注意穿戴NEW[警报]这家医院的名字的"欺诈"

新闻
自4月6日星期一起重新开始乳腺外科的治疗

新闻
2025年度医院饮食的患者满意度调查结果的通知

跟放的扒手
2025年度第2次横滨市鹤见地区化疗药药联合conference的通知

跟放的扒手
2025年度第1次横滨市鹤见地区化疗药药联合conference的通知

跟放的扒手
在在院以外的药房受到药物的交付时候的自己负担的新的结构从2024年10月开始

跟放的扒手
在这家医院,正推进生物后续品的使用

跟放的扒手
2024年度第1次横滨市鹤见地区化疗药药联合conference召开的通知

朝医护人员、学生的方向
关于新人护理人员训练"医疗机关纳入进修"

朝医护人员、学生的方向
2026年度"实习领导者培训讲习会"开课的通知

朝医护人员、学生的方向
关于2026年度"为专业以营养支持队的医士临床实施锻炼"希望者纳入

朝医护人员、学生的方向
[合格发表]认定护理教育课程儿童初期关怀专业2026年度入学考试考试

朝医护人员、学生的方向
在2026年度开始"儿童初期关怀认定护士课程"招募(次要考试)了
活动

患者、一般的对象
在6/14(星期日)举行NEW[参加者招募]第4次"向日葵的会"

患者、一般的对象
在5/14(星期四)举行NEW[参加者招募]癌患者的聚会癌沙龙"散步道路"

患者、一般的对象
[活动报告]市民公开讲座"心脏病的的为预防"能够

医护人员对象
[活动报告]举行了"心血管疾病地区治疗战略2026"

患者、一般的对象
为3/9(星期一)心脏病的预防完成





 0570-00-7500
0570-00-7500






























